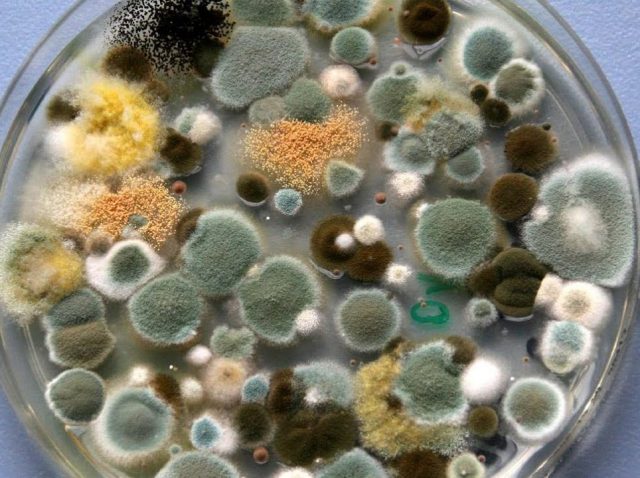

Contenido
- 1 Cual es el peligro de la enfermedad
- 2 Los agentes causantes de la aspergilosis en las abejas.
- 3 Métodos de infección
- 4 Signos de infección
- 5 Métodos de diagnóstico
- 6 Cómo y cómo tratar la cría de piedra en las abejas.
- 7 Procesamiento de colmenas e inventario
- 8 Un conjunto de medidas preventivas.
- 9 Conclusión
La aspergilosis de las abejas (cría de piedra) es una enfermedad fúngica de las larvas de abejas de todas las edades y también de las abejas adultas. Aunque el agente causante de esta infección es de naturaleza muy común, la enfermedad de las abejas rara vez se encuentra en la industria apícola. Su aparición suele estar asociada con un período de flujo de miel activo o con un clima primaveral húmedo. Pero las consecuencias de la infección pueden ser nefastas. Para evitar que esto suceda, debe tomar medidas para combatir el hongo lo antes posible.
Cual es el peligro de la enfermedad
La aspergilosis de las abejas se puede propagar muy rápidamente. Habiendo aparecido en una familia, en pocos días la infección puede afectar a todas las colmenas del colmenar. La enfermedad es igualmente peligrosa para las abejas, las aves, los animales y los seres humanos. La enfermedad afecta las membranas mucosas de los órganos de la visión y la respiración, principalmente los bronquios y los pulmones, así como la piel.
Una vez en el cuerpo de la larva, las esporas de aspergilosis actúan sobre ella de dos formas:
- el micelio crece a través del cuerpo de la larva, debilitándolo y secándolo;
- Se produce una toxina que tiene un efecto destructivo sobre el tejido nervioso y muscular de la cría.
Después de unos días, las larvas mueren. Aspergillus ingresa al cuerpo de la cría y las abejas junto con la comida o a través de daños externos en el cuerpo.
Los agentes causantes de la aspergilosis en las abejas.
La enfermedad es causada por el hongo amarillo y mohoso Aspergillus (Aspergillus flavus), que está muy extendido en la naturaleza, con menos frecuencia por sus otras variedades: Aspergillus niger y Aspergillus fumigatus. El hongo se desarrolla en plantas y restos orgánicos muertos. Es un micelio de fibras largas de hifas, que se elevan por encima del medio nutritivo en 0,4-0,7 mm y tienen cuerpos fructíferos en forma de un engrosamiento transparente. Las colonias de Aspergillus flavus son de color amarillo verdoso y el niger es de color marrón oscuro.
Métodos de infección
Las esporas del hongo Aspergillus viven en casi todas partes: en el suelo, en su superficie, en plantas vivas y muertas. Al estar en las anteras y en los nectarios de las flores, las esporas, junto con el polen, son recogidas por las abejas recolectoras y entregadas a las colmenas. Además, las abejas obreras en sus patas y pelos los transfieren fácilmente, los transfieren a otros adultos y larvas durante la cosecha y la alimentación. El hongo se multiplica en panales, pan de abeja, larvas, pupas, abejas adultas.
Las siguientes condiciones contribuyen a la manifestación de la aspergilosis:
- temperatura del aire desde +250Desde hasta +450DESDE;
- humedad superior al 90%;
- clima lluvioso;
- hierba grande
- la ubicación de las casas en suelo húmedo;
- una colonia de abejas debilitada;
- mal aislamiento de las colmenas.
La aspergilosis de abejas más común en primavera y verano, ya que es durante este período que aparecen todas las circunstancias que provocan la enfermedad.
Signos de infección
Puede averiguar sobre la aparición de crías de piedra en las abejas por la apariencia y el estado de las larvas. El período de incubación dura de 3 a 4 días. Y en el día 5-6, la cría muere. Habiendo ingresado al cuerpo de la larva a través de la cabeza o entre los segmentos, el hongo crece y lo cambia hacia afuera. La larva adquiere un color crema claro, arrugada y sin gajos. Debido al hecho de que la humedad en la larva es absorbida activamente por el micelio del hongo, la pupa se seca y se siente sólida (cría de piedra).
El hongo en la superficie de la larva muerta forma esporas y, según el tipo de hongo, la larva se vuelve verde claro o marrón oscuro.Dado que el micelio del hongo llena firmemente las células, las larvas no se pueden eliminar de allí. Cuando la enfermedad está avanzada, el hongo cubre toda la cría, las cubiertas de las células parecen haber fallado.
Las abejas adultas se ven afectadas con mayor frecuencia por la aspergilosis en la primavera. Primero se agitan y se mueven activamente, su respiración abdominal aumenta. Al poco tiempo, las abejas enfermas se debilitan, no pueden permanecer en las paredes de los panales, caen y mueren al cabo de unas horas. Externamente, los insectos con aspergilosis casi no difieren de los sanos. Solo su vuelo se vuelve más pesado y más débil.
El micelio del hongo, que crece en los intestinos, impregna todo el cuerpo de una abeja adulta. También crece detrás de la cabeza en forma de una especie de collar. Al apretar el abdomen y el pecho de un insecto muerto, se comprueba que se han endurecido. Las abejas muertas parecen más peludas debido a la germinación del moho.
Métodos de diagnóstico
El diagnóstico de aspergilosis de abejas se realiza sobre la base de los signos externos característicos de la cría y los adultos muertos, así como después de estudios microscópicos y micológicos. Los resultados de la investigación están listos en 5 días.
Al menos 50 abejas enfermas o cadáveres recién muertos y un trozo (10x15 cm) de panal con cría enferma y muerta se envían al laboratorio veterinario en frascos de vidrio con tapa hermética. La entrega del material debe realizarse dentro de las 24 horas siguientes al momento de su recogida.
En el laboratorio, se realizan raspados de cadáveres de larvas y abejas para identificar la esporulación del hongo aspergilosis. Al realizar investigaciones de laboratorio, se excluye la enfermedad de la ascoferosis.
Cómo y cómo tratar la cría de piedra en las abejas.
Cuando el laboratorio veterinario confirma la enfermedad "aspergilosis", el colmenar se declara disfuncional y se pone en cuarentena. En caso de daños menores, las abejas y las crías se tratan en consecuencia. También desinfectan toda la granja de abejas.
En casos aislados de muerte de las larvas, los panales, junto con las abejas, se trasladan a una colmena seca, tibia y desinfectada. Luego, la aspergilosis de las abejas se trata con medicamentos especiales, como en la ascoferosis, aprobados por el Departamento de Medicina Veterinaria:
- Astemizol;
- "Askosan";
- "Askovet";
- "Unisan".
De todos los medicamentos enumerados, solo Unisan se puede usar solo. En otros casos, se recomienda confiar el tratamiento a especialistas.
Para usar "Unisan", el agente en un volumen de 1,5 ml se agita en 750 ml de jarabe de azúcar preparado mezclando azúcar y agua en una proporción de 1: 4. La solución "Unisan" se rocía con:
- las paredes de la colmena en el interior;
- panales poblados y vacíos;
- marcos en ambos lados;
- colonias de abejas con cría;
- equipo y ropa de trabajo del apicultor.
El procedimiento se repite 3-4 veces cada 7-10 días. El procesamiento debe completarse 20 días antes del inicio de la recolección de miel. "Unisan" es un producto seguro para los humanos. Después de este tratamiento, la miel es buena para el consumo.
Antes del inicio del tratamiento para la aspergilosis de las abejas, se intensifican las colonias enfermas. Si el útero está enfermo, se cambia a uno sano, el nido se acorta y se aísla, y se organiza una buena ventilación. A las abejas se les proporciona suficiente miel. Con la falta de miel, se alimentan con un 67% de jarabe de azúcar.
Cuando se trabaja con abejas infectadas, los apicultores, para evitar el contacto de las esporas de hongos en las membranas mucosas, deben tomar todas las precauciones y usar una bata, un vendaje de gasa húmedo de 4 capas en la nariz y la boca y gafas en los ojos. Después de terminar el trabajo, debe lavarse la cara y las manos con jabón y hervir la ropa de trabajo.
Procesamiento de colmenas e inventario
Si las colonias de abejas se ven gravemente afectadas por la aspergilosis, se destruyen al encenderlas con dióxido de azufre o formalina y se quema el material aislante con solapas y marcos de panal. Dada la rápida propagación de la aspergilosis de las abejas, así como el peligro de la enfermedad para todo el colmenar, se lleva a cabo el siguiente procesamiento de colmenas y equipos:
- limpiar físicamente de escombros, cadáveres de abejas y larvas, propóleo, cera, moho y hongos;
- tratado con una solución de formaldehído al 5% o con llama de soplete;
- el suelo debajo de las colmenas se desentierra con la adición de una solución de formaldehído al 4% o una solución clarificada de lejía;
- Las batas, las redes faciales y las toallas se desinfectan hirviéndolas durante media hora o se sumergen en una solución de peróxido de hidrógeno al 2% durante 3 horas, luego se lavan y se secan.
Para procesar la colmena con una solución de formalina al 5%, agregue 50 ml de la sustancia, 25 g de permanganato de potasio y 20 ml de agua en un recipiente pequeño. Coloque el recipiente en la colmena durante 2 horas. Luego, trate la colmena con amoníaco al 5% para eliminar los vapores de formalina.
En lugar de un soplete, puede usar una pistola de aire caliente de construcción. El uso de una pistola de aire caliente elimina el riesgo de incendio y la temperatura del aire puede alcanzar los + 80ºC.0DESDE.
Después de realizar las medidas de desinfección, las colmenas y todo el equipo se lavan bien y se secan completamente. Si los peines aún se pueden usar, entonces se tratan de la misma manera que todo el inventario. En caso de una infección fúngica grave, el panal se funde sobre cera con fines técnicos.
La cuarentena se retira un mes después de la completa destrucción de la aspergilosis de abejas en el colmenar.
Un conjunto de medidas preventivas.
Para prevenir la enfermedad de la aspergilosis de las abejas y las crías, debe cumplir con ciertas reglas y tomar una serie de medidas preventivas:
- antes de instalar las colmenas, debe procesar la parcela de tierra con cal para desinfectarla;
- mantén solo familias fuertes en el colmenar;
- el colmenar debe ubicarse en lugares secos y bien iluminados;
- evite la hierba densa;
- reduzca los nidos para el invierno y aíslelos bien;
- durante la ausencia de recolección de miel, proporcione a las abejas alimento completo;
- mantener las casas limpias, ventiladas y secas;
- no realice ninguna actividad con urticaria en climas fríos y húmedos;
- no use antibióticos para fortalecer las colonias de abejas, que debilitan la inmunidad de los insectos.
La alta humedad en las colmenas en cualquier época del año es el peor enemigo de las abejas y puede provocar enfermedades mortales. Por lo tanto, el colmenar debe tener casas secas y cálidas durante todo el año.
Conclusión
La aspergilosis de las abejas es una enfermedad peligrosa para cualquier granja de abejas. Puede afectar no solo a las crías, sino también a las abejas adultas. Todo apicultor necesita conocer los signos de esta enfermedad, los métodos de tratamiento y las precauciones para tratarla de manera oportuna y eficaz.